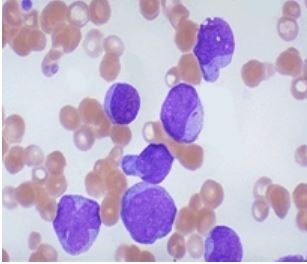
radiation

Symptoms of Radiation Exposure and How to Respond
As concerns over radioactive leaks from the Fukushima nuclear power plant in Japan continue to grow, public interest in the symptoms of radiation exposure and proper response measures is also increasing. If radioactive materials were to spread into neighboring countries, how should people respond?
.
.
.
.
Increased Risk of Leukemia and Thyroid Cancer
The health effects of radiation exposure are generally classified into acute and chronic effects.
Acute symptoms, which appear within 1–2 hours and may last for 1–2 days after exposure, include acute radiation syndrome, skin injuries, and dysfunction of blood-forming organs. Early symptoms of acute radiation syndrome include nausea, vomiting, and severe fatigue.
In cases of localized exposure, acute symptoms may include hair loss, inflammation, redness, blisters, and ulcers. Even if recovery occurs, high absorbed doses can lead to long-term health effects such as leukemia, skin cancer, cataracts, shortened lifespan, and other malignant diseases.
Radiation can also cause mutations in genetic material (DNA), increasing the risk of cancer, birth defects, and hereditary diseases.
In numerical terms, a one-time whole-body exposure of 500 millisieverts (mSv) may cause a temporary decrease in white blood cells (lymphocytes). By comparison, the average person is naturally exposed to about 2.4 mSv per year in daily life.
At an exposure level of 1 sievert (1 Sv = 1,000 mSv), symptoms such as nausea, vomiting, general weakness, and serious blood cell damage may occur. At 2 Sv, the mortality rate is approximately 5%. At 5 Sv, about 50% of exposed individuals may die within one month. Exposure to 6 Sv results in a 90% mortality rate within two weeks, while 10 Sv is considered fatal to 100% of exposed individuals within several weeks.
Even when acute symptoms are treated with medications such as potassium iodide (KI) or Prussian blue at exposure levels below 5 Sv, various cancers—including leukemia, thyroid cancer, and breast cancer—may develop after a latent period of 10 to 30 years.
.
.
Seek Immediate Shelter Indoors During an Emergency
Radiation is invisible, odorless, tasteless, and cannot be felt by the human body, making it difficult to detect without proper equipment.
When an emergency alert is issued, it is important not to panic and to follow the instructions of emergency response personnel. If you are outdoors or working outside, return home immediately, close all windows, and stay indoors while listening to official emergency broadcasts.
If radiation exposure occurs while indoors, close all doors and windows tightly and turn off ventilation systems, fans, and air conditioners. Even if family members are at school or work, they will follow their own evacuation procedures—do not leave home to look for them.
Prepare basic daily necessities, shut off electricity, gas, and water to reduce fire risk, and place a white cloth or towel outside your home to indicate that evacuation is complete.
In areas far from the source, the amount of radioactive material may be minimal. Following basic precautions—such as wearing a mask, changing clothes, showering, using an umbrella, and avoiding outdoor exposure—can significantly reduce health risks.
If exposure is suspected, remove contaminated clothing immediately and wash any affected areas thoroughly. In cases of significant internal contamination, medications such as stable iodine or Prussian blue may be administered. The Korea Institute of Nuclear Safety recommends following the guidelines below if radioactive fallout is expected.

.
.
Guidelines in Case of Radioactive Fallout
-
Radiation cannot be detected by human senses; avoid personal judgment or impulsive actions
-
Fully trust official government instructions via radio, television, or civil defense organizations
-
Stay indoors and avoid going outside; follow emergency personnel guidance if evacuation is required
-
Avoid rain exposure; carry an umbrella or raincoat if going outside is unavoidable
-
Cover wells, water containers, and food storage jars
-
Move food indoors and do not eat outdoors
-
Consume only approved food supplies or those that have passed contamination inspection
-
Move livestock into shelters and cover animal feed with plastic sheets
-
Wash vegetables and fruits thoroughly before consumption
-
Keep windows closed to minimize the intake of outside air

.
.
What Preventive Measures Are in Place in South Korea?
South Korea operates a national radiation emergency medical system centered on the National Radiation Emergency Medical Center at the Korea Institute of Radiological and Medical Sciences. A network of 21 designated hospitals supports emergency treatment nationwide.
The system includes 386 personal radiation dosimeters, 257 contamination monitors and radionuclide analyzers, and 410 trained emergency medical personnel.
Radiation contamination detectors have been installed at Incheon International Airport and Gimpo International Airport since March 17, and monitoring systems are also operating at ports nationwide. As of March 22, only two individuals out of 39,958 screened were found to have minor external contamination.
